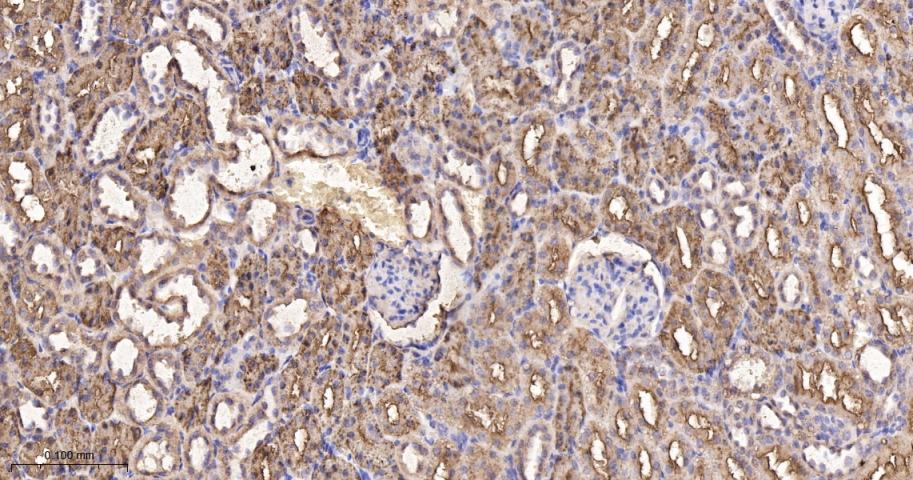
磷酸羧化酶2重组兔单抗
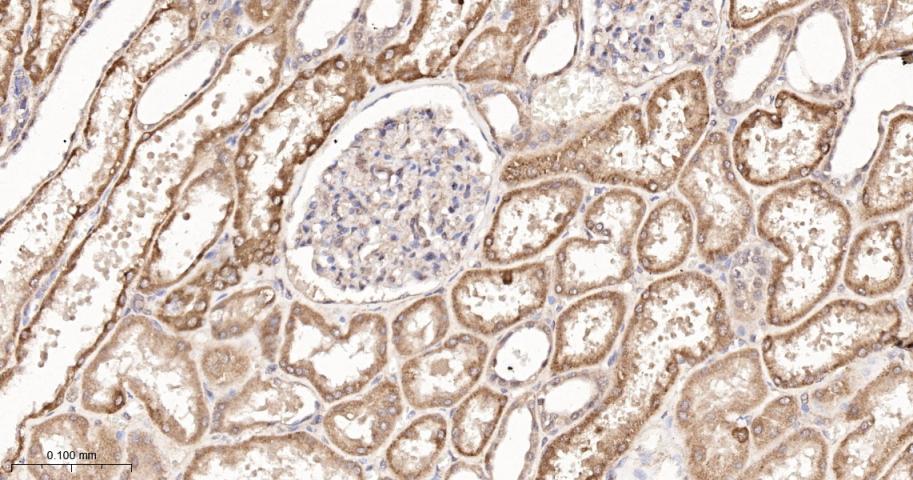
磷酸羧化酶2重组兔单抗
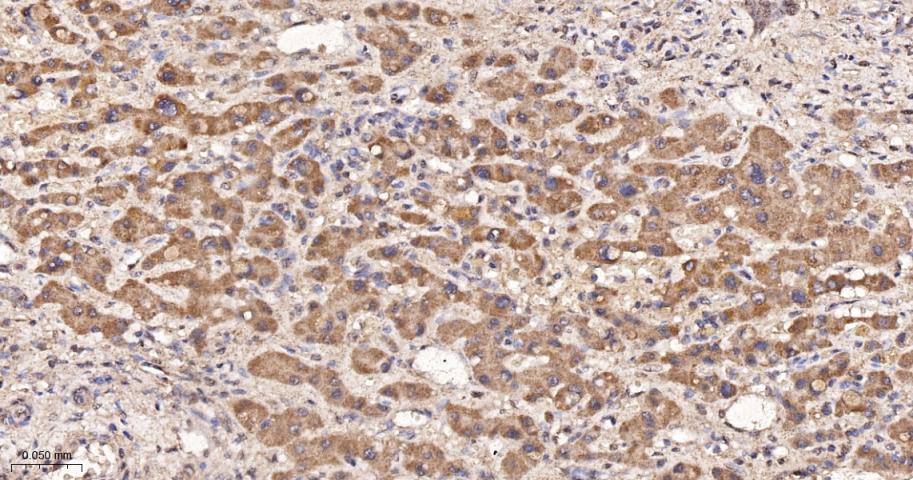
磷酸羧化酶2重组兔单抗

磷酸羧化酶2重组兔单抗
Rrmab?兔单抗

货号:bsm-60457R
产品详情
相关标记
相关产品
相关文献
常见问题
概述
产品编号
bsm-60457R
产品类型
重组兔单抗
英文名称
PCK2 Recombinant Rabbit mAb
中文名称
磷酸羧化酶2重组兔单抗
英文别名
PCKGM_HUMAN; PCK2; PEPCK-M; Phosphoenolpyruvate carboxykinase 2, mitochondrial (mtPCK2); 4.1.1.32; PEPCK2; PEPCK; mtPCK2;
抗体来源
Rabbit
亚型
IgG/Kappa
性状
Liquid
纯化方法
affinity purified by Protein A
克隆类型
Recombinant
克隆号
E6C11
浓度
1mg/ml
储存液
0.01M TBS (pH7.4) with 1% BSA, 0.02% Proclin300 and 50% Glycerol.
研究领域
Cancer > Cancer Metabolism > Metabolic signaling pathway > Metabolism of carbohydrates
Cardiovascular > Lipids / Lipoproteins > Lipid Metabolism > Cholesterol Metabolism
Metabolism > Pathways and Processes > Metabolic signaling pathways > Carbohydrate metabolism
Metabolism > Pathways and Processes > Metabolic signaling pathways > Lipid and lipoprotein metabolism > Cholesterol Metabolism
Metabolism > Pathways and Processes > Mitochondrial Metabolism > Mitochondrial markers
Metabolism > Types of disease > Obesity
Signal Transduction > Metabolism > Mitochondrial
Signal Transduction > Protein Phosphorylation > Ser / Thr Kinases > PKC
保存条件
Shipped at 4℃. Store at -20℃ for one year. Avoid repeated freeze/thaw cycles.
注意事项
This product as supplied is intended for research use only, not for use in human, therapeutic or diagnostic applications.
背景资料
PCK2 is a a member of the phosphoenolpyruvate carboxykinase (GTP) family. The protein is a mitochondrial enzyme that catalyzes the conversion of oxaloacetate to phosphoenolpyruvate in the presence of GTP. A cytosolic form encoded by a different gene has also been characterized and is the key enzyme of gluconeogenesis in the liver. The encoded protein may serve a similar function, although it is constitutively expressed and not modulated by hormones such as glucagon and insulin that regulate the cytosolic form. Alternatively spliced transcript variants have been described.

产品应用
| 应用 | 已检合格种属 | 预测种属 | 推荐稀释比例 |
|---|---|---|---|
| WB | Human, Mouse, Rat | 1:500-2000 | |
| IHC-P | Human, Mouse, Rat | 1:100-500 | |
| IHC-F | Human, Mouse, Rat | 1:100-500 | |
| IF | Human, Mouse, Rat | 1:100-500 | |
| Flow-Cyt | Human | Mouse, Rat | 1:50-100 |
交叉反应
交叉反应: Human, Mouse, Rat
相关产品
暂无相关产品
靶标
基因名
PCK2
蛋白名
phosphoenolpyruvate carboxykinase [GTP], mitochondrial
亚基
Monomer.
亚细胞定位
Mitochondrion.
翻译后修饰
Phosphorylated upon DNA damage, probably by ATM or ATR.
疾病
Defects in PCK2 are the cause of mitochondrial phosphoenolpyruvate carboxykinase deficiency (M-PEPCKD) [MIM:261650]. A metabolic disorder resulting from impaired gluconeogenesis. It is a rare disease with less than 10 cases reported in the literature. Clinical characteristics include hypotonia, hepatomegaly, failure to thrive, lactic acidosis and hypoglycemia. Autoposy reveals fatty infiltration of both the liver and kidneys. The disorder is transmitted as an autosomal recessive trait.
相似性
Belongs to the phosphoenolpyruvate carboxykinase [GTP] family.
功能
Catalyzes the conversion of oxaloacetate (OAA) to phosphoenolpyruvate (PEP), the rate-limiting step in the metabolic pathway that produces glucose from lactate and other precursors derived from the citric acid cycle (By similarity).
标记抗体
暂无标记数据
同靶标产品
暂无同靶标产品
相关文献
提示: 发表研究结果有使用 bsm-60457R 时请让我们知道,以便我们可以引用参考文章。作为回馈,资料提供者将获得我们送上的小礼品。
暂无相关文献
常见问题
暂无常见问题